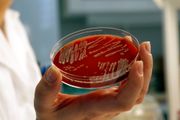

Mine artikler
Her er operativsystemene som skal utfordre Android
25. nov. 2013

Narvik-studenter venter på svar etter satellitt-oppskyting
22. nov. 2013

Skift powerpoint-slide ved å heve øyenbrynene
22. nov. 2013

– Norske ingeniører kan for lite om solenergi
22. nov. 2013

Norsk solinnstråling er opptil 10 prosent høyere enn tidligere antatt
20. nov. 2013

Slik gjør du deg attraktiv på LinkedIn
19. nov. 2013

Luftskip, luftputefartøy, helikopter og fly i ett
18. nov. 2013

Norman Sharks nye partner angivelig brukt av Assad-regimet
12. nov. 2013

– Hadde ikke fått denne avtalen om vi ikke var best
12. nov. 2013

Slik kan du bygge roboter uten koding
10. nov. 2013

Bytter ut kull og diesel med solceller på Svalbard
8. nov. 2013

Dette flyet kan fly New York-London på under én time
6. nov. 2013

– Kommersialisering av kald fusjon er nært forestående
5. nov. 2013

Forskere har fått E. coli-bakterier til å lage bensin
4. nov. 2013
Nytt vindu kan generere strøm
3. nov. 2013
